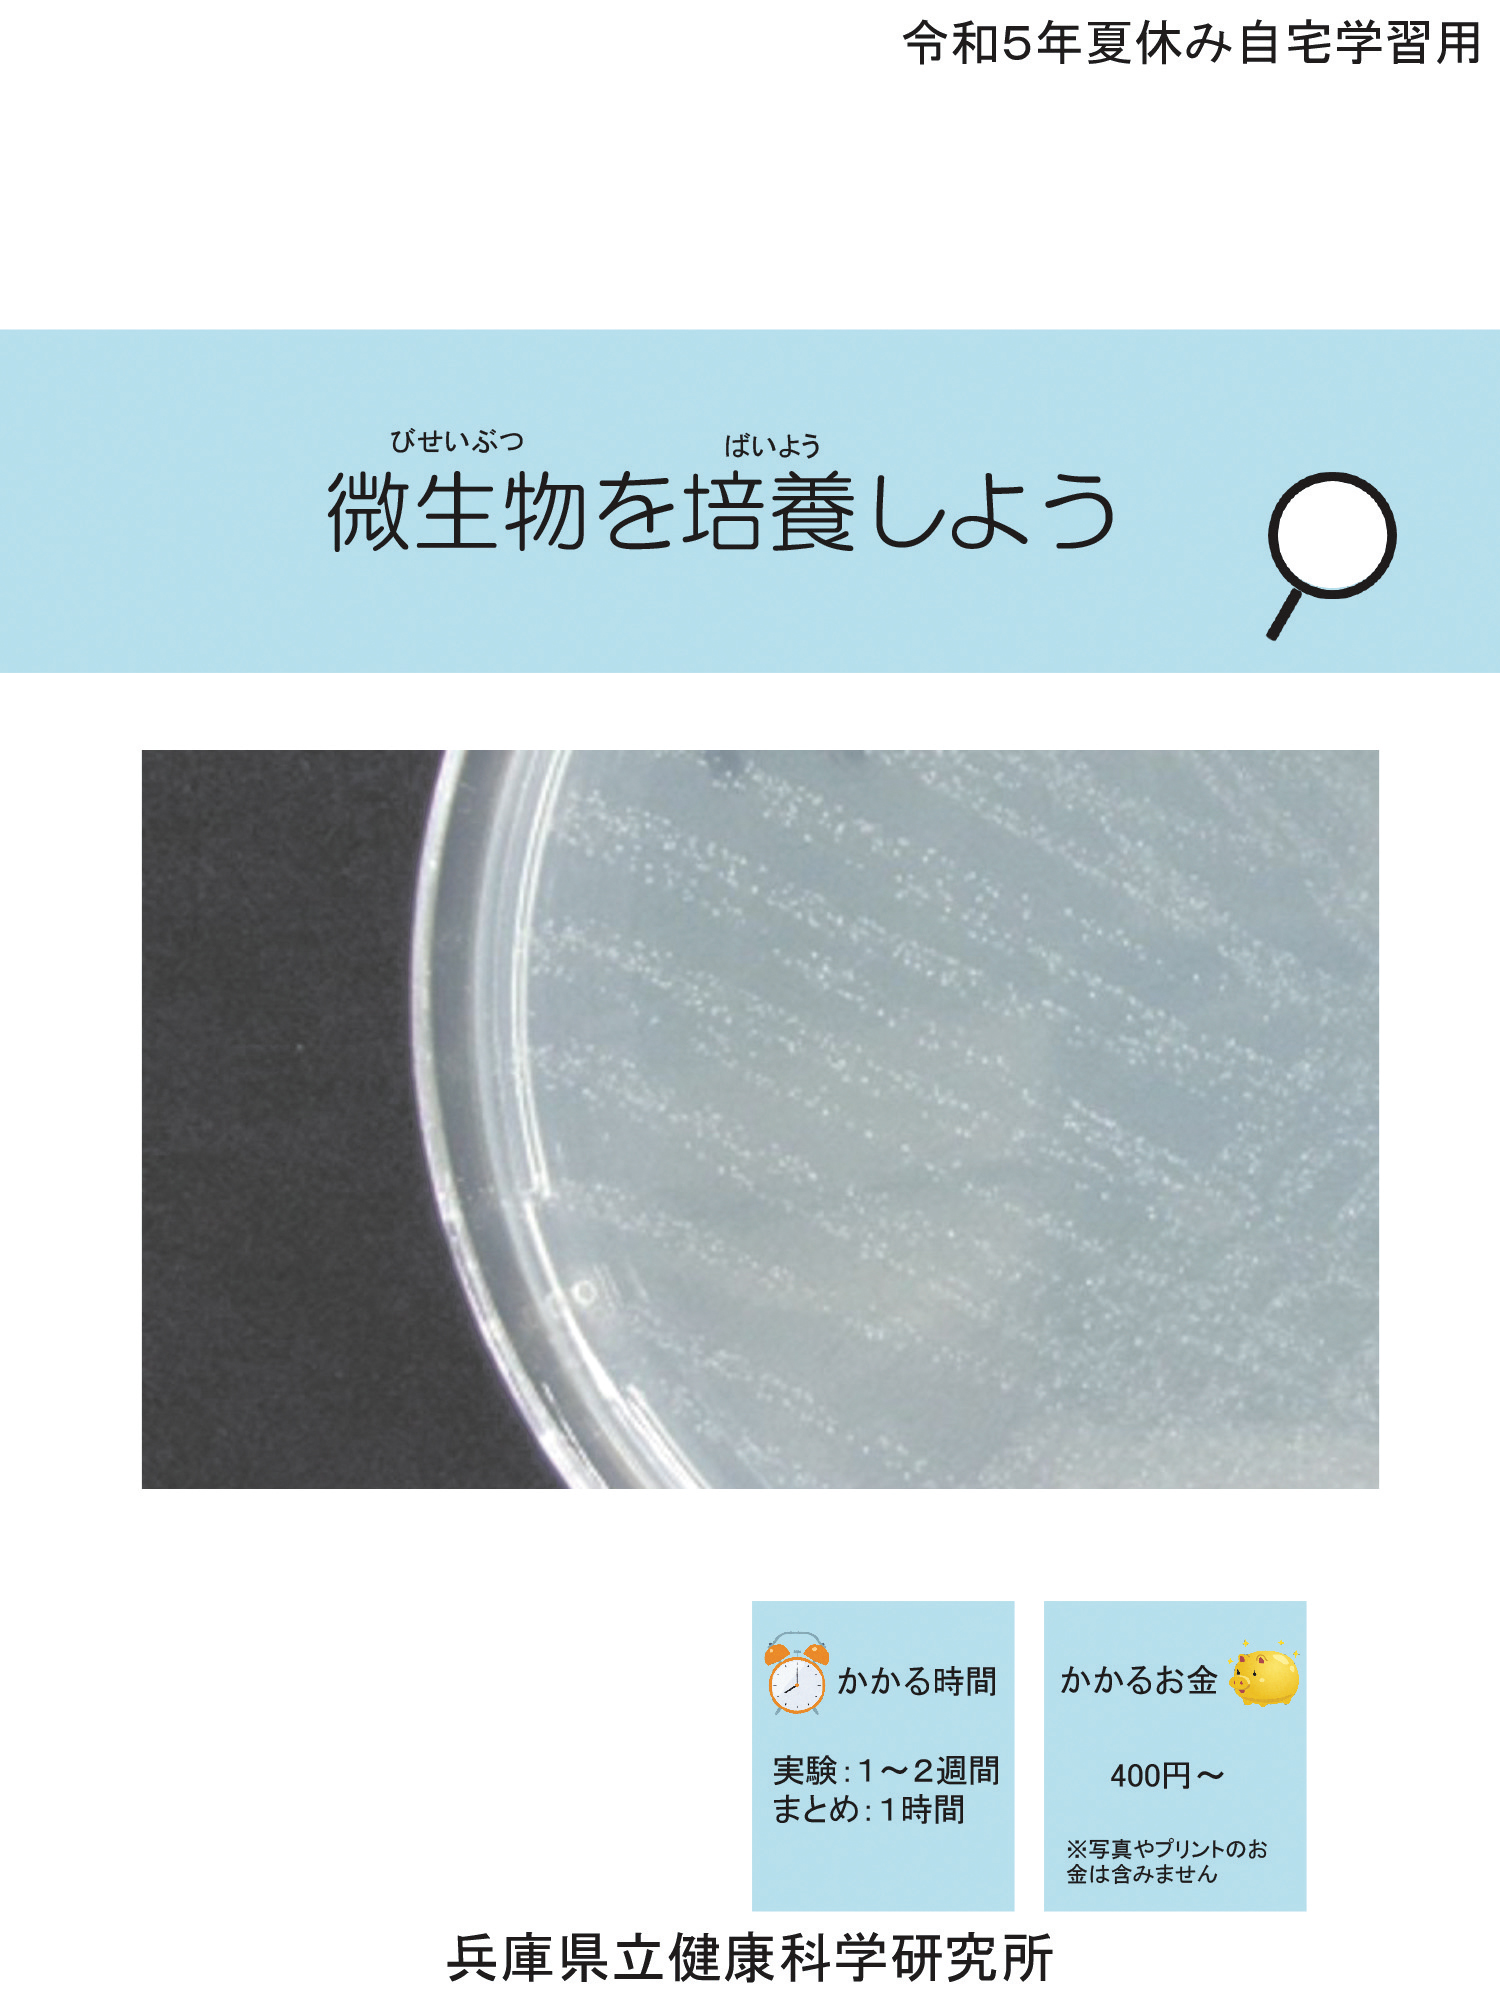
微生物を培養しよう

ここから本文です。

県立健康科学研究所では小・中学生の夏休みの自由研究に役立ててもらおうと、ホームページに実験テキストを掲載しています。テキストを基に実験し、結果をまとめたリポートを提出していただいた全員に修了証と記念品を進呈します。実験テーマは研究員がそれぞれの専門性を生かして考案。身近にある道具を使ってチャレンジできる5種類を用意しました。「科学」と聞くと難しく感じるかもしれませんが、身の回りの「なぜ?」や「どうして?」を調べることから科学に親しんでもらえるとうれしいです。小・中学生の皆さんの応募をお待ちしています!
(同研究所 雜賀祥美さん)

実験テキスト(主な対象)
|
テキストのダウンロードはこちら |
|
大橋秀隆所長 |
当研究所は1948(昭和23)年の開設以来、“県民生活の安全と安心の確保”を掲げ、感染症や食品、医薬品、飲料水など公衆衛生に関する調査研究や試験検査に取り組み、その結果を広く発信しています。コロナ禍の初期、医療機関の検査体制が整うまでは県所管の全ての検体検査を担いました。少しは当研究所の名前を耳にされた方もいるのではないでしょうか。また、テレビや新聞で花粉情報が報道されるのも、当研究所が県内5カ所の計測値を基に情報を提供しているからです。このたび、当研究所をもっと身近に感じていただけたらと、「サマーチャレンジ」を企画しました。来年度以降、見学会や科学イベントなども計画しています。ぜひ、ご参加ください。
|
新型コロナウイルスRNA遺伝子の抽出作業の様子。 |

